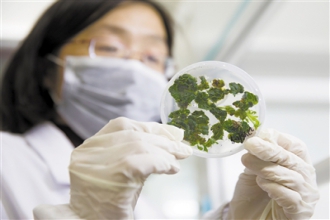

|
这里猕猴桃种质资源最丰富科技日报 2019-03-26 |

中科院武汉植物园国家猕猴桃种质资源圃收集保存有61个种或变种的猕猴桃属植物,包含110余个栽培品种、3万余株种内种间杂交群体,在资源收集数量和保存规模上是目前国内外该属植物遗传多样性涵盖量最大、种质资源最丰富的基因库。图为近日,在中科院武汉植物园国家猕猴桃种质资源圃组织培养室,科研人员展示猕猴桃愈伤组织再生芽。金立旺/摄
责任编辑:杨茗
下一篇:蓝藻人造叶片原型系统问世
 科普中国APP
科普中国APP
 科普中国微信
科普中国微信
 科普中国微博
科普中国微博

最新文章
-
为何太阳系所有行星都在同一平面上旋转?
新浪科技 2021-09-29
-
我国学者揭示早期宇宙星际间重元素起源之谜
中国科学报 2021-09-29
-
比“胖五”更能扛!我国新一代载人运载火箭要来了
科技日报 2021-09-29
-
5G演进已开始,6G研究正进行
光明日报 2021-09-28
-
“早期暗能量”或让宇宙年轻10亿岁
科技日报 2021-09-28
-
5G、大数据、人工智能,看看现代交通的创新元素
新华网 2021-09-28













